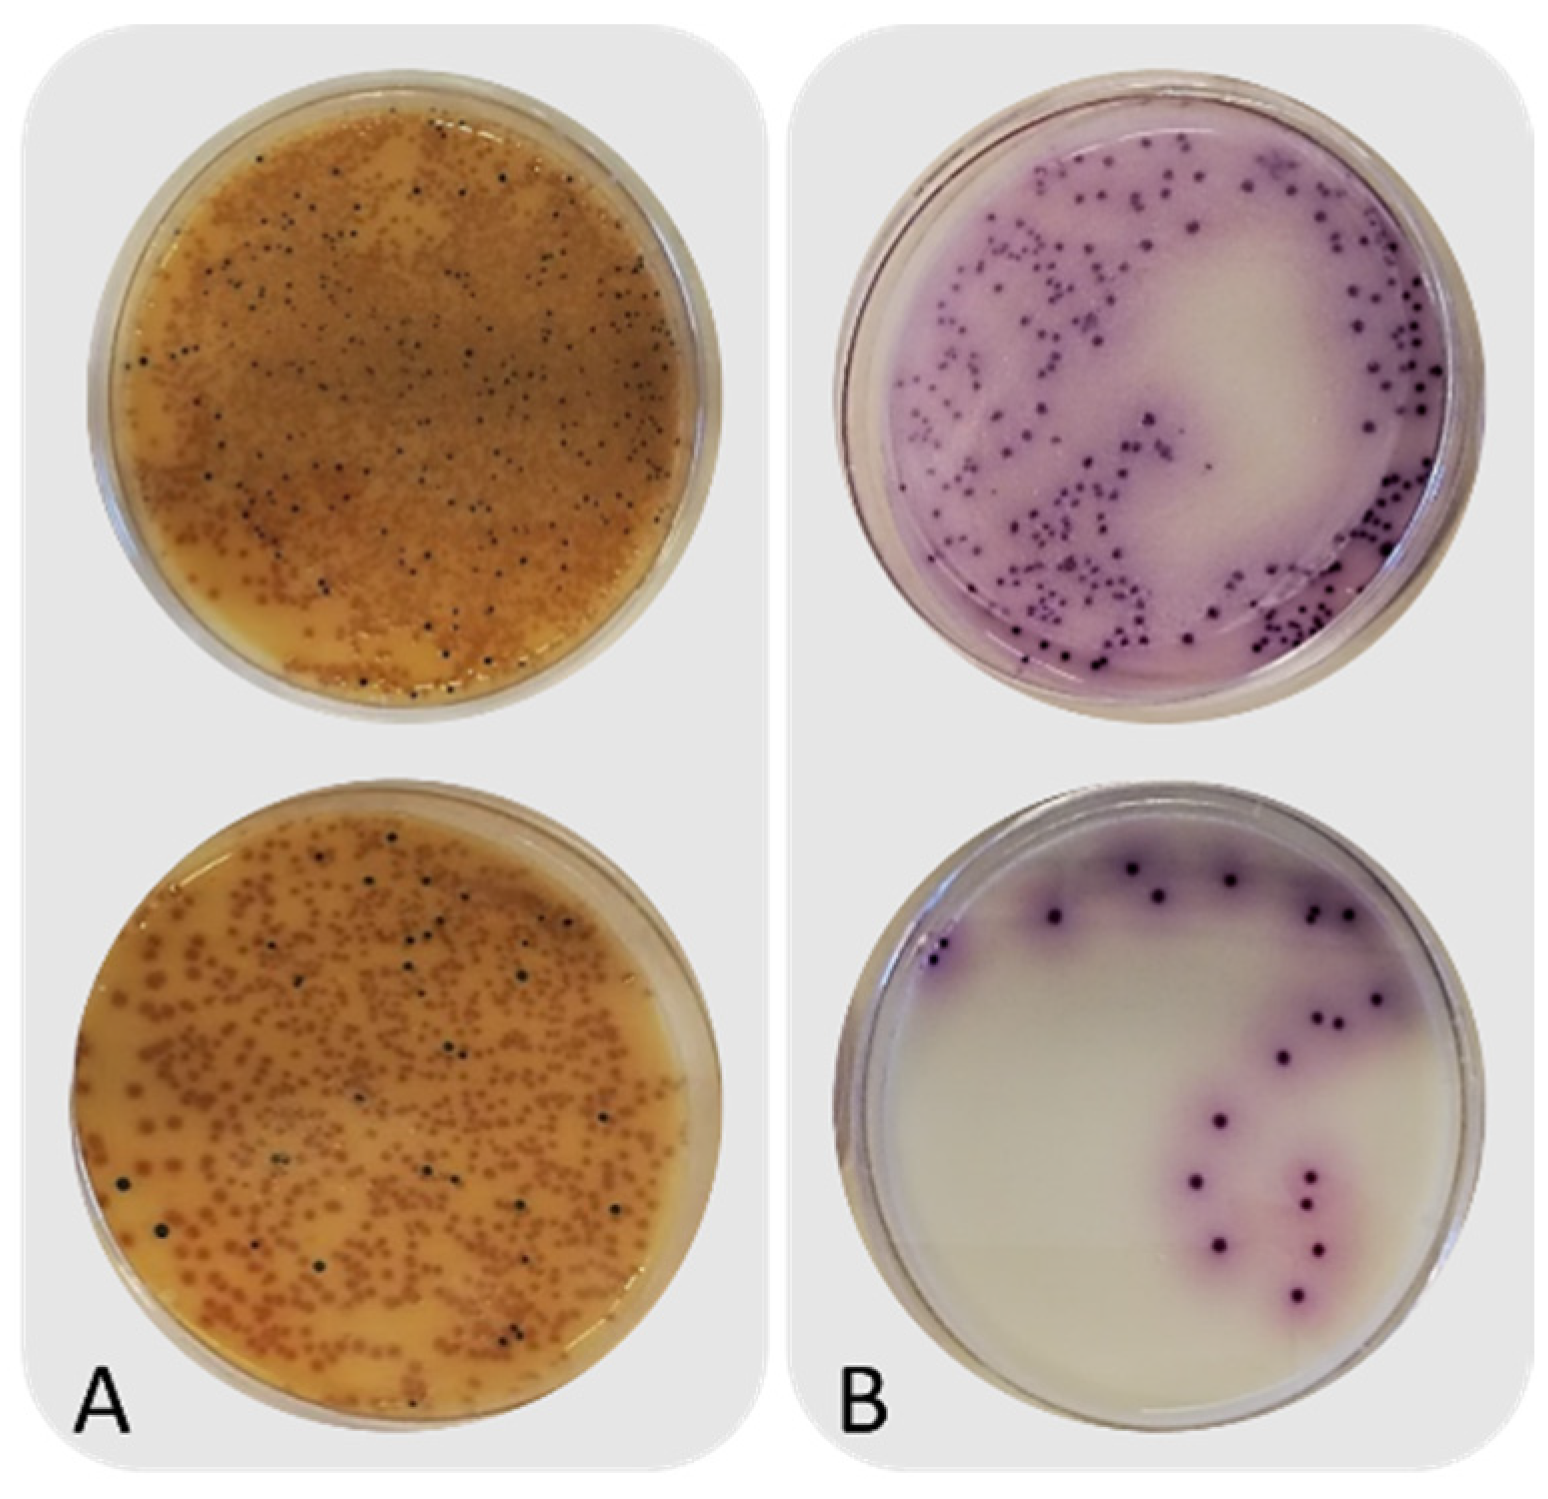
Insects 13 00022 g0a1

Impact of Heat Treatment on the Microbiological Quality of Frass Originating from Black Soldier Fly Larvae (Hermetia illucens)
Abstract
:Simple Summary
Abstract
1. Introduction
2. Materials and Methods
2.1. Black Soldier Fly Larvae Rearing Conditions and Frass Generation
2.2. Experimental Set-Up, Heat Treatment and Samping
2.3. Bacterial Strains and Inoculation
2.4. Determination of Intrinsic Parameters
2.5. Microbiological Analyses
2.6. Statistical Analyses
3. Results
3.1. Intrinsic Parameters and Microbiological Counts of Untreated Frass
3.2. Microbial Counts before and after Heat Treatment of Frass
4. Discussion
4.1. Microbiological Quality of Untreated Frass
4.2. Impact of Heat Treatment on Microbiological Quality of Frass
5. Conclusions
Supplementary Materials
Author Contributions
Funding
Institutional Review Board Statement
Informed Consent Statement
Data Availability Statement
Acknowledgments
Conflicts of Interest
Appendix A

References
- Diener, S.; Zurbrügg, C.; Tockner, K. Conversion of organic material by black soldier fly larvae: Establishing optimal feeding rates. Waste Manag. Res. 2009, 27, 603–610. [Google Scholar] [CrossRef] [PubMed]
- Makkar, H.P.S.; Tran, G.; Heuzé, V.; Ankers, P. State-of-the-art on use of insects as animal feed. Anim. Feed Sci. Technol. 2014, 197, 1–33. [Google Scholar] [CrossRef]
- De Smet, J.; Wynants, E.; Cos, P.; Van Campenhout, L. Microbial community dynamics during rearing of black soldier fly larvae (Hermetia illucens) and impact on exploitation potential. Appl. Environ. Microbiol. 2018, 84, 1–17. [Google Scholar] [CrossRef] [Green Version]
- Chavez, M.; Uchanski, M. Insect left-over substrate as plant fertiliser. J. Insects Food Feed 2021, 7, 683–694. [Google Scholar] [CrossRef]
- Čičková, H.; Newton, G.L.; Lacy, R.C.; Kozánek, M. The use of fly larvae for organic waste treatment. Waste Manag. 2015, 35, 68–80. [Google Scholar] [CrossRef] [PubMed]
- Fischer, H.; Romano, N. Fruit, vegetable, and starch mixtures on the nutritional quality of black soldier fly (Hermetia illucens) larvae and resulting frass. J. Insects Food Feed 2021, 7, 319–327. [Google Scholar] [CrossRef]
- Schmitt, E.; de Vries, W. Potential benefits of using Hermetia illucens frass as a soil amendment on food production and for environmental impact reduction. Curr. Opin. Green Sustain. Chem. 2020, 25, 100335. [Google Scholar] [CrossRef]
- Poveda, J. Insect frass in the development of sustainable agriculture. A review. Agron. Sustain. Dev. 2021, 41, 5. [Google Scholar] [CrossRef]
- Beesigamukama, D.; Mochoge, B.; Korir, N.K.; Fiaboe, K.K.M.; Nakimbugwe, D.; Khamis, F.M.; Subramanian, S.; Dubois, T.; Musyoka, M.W.; Ekesi, S.; et al. Exploring black soldier fly frass as novel fertilizer for improved growth, yield, and nitrogen sse efficiency of maize under field conditions. Front. Plant Sci. 2020, 11, 574592. [Google Scholar] [CrossRef]
- Chirere, T.E.S.; Khalil, S.; Lalander, C. Fertiliser effect on Swiss chard of black soldier fly larvae-frass compost made from food waste and faeces. J. Insects Food Feed 2021, 7, 457–469. [Google Scholar] [CrossRef]
- Setti, L.; Francia, E.; Pulvirenti, A.; Gigliano, S.; Zaccardelli, M.; Pane, C.; Caradonia, F.; Bortolini, S.; Maistrello, L.; Ronga, D. Use of black soldier fly (Hermetia illucens (L.), Diptera: Stratiomyidae) larvae processing residue in peat-based growing media. Waste Manag. 2019, 95, 278–288. [Google Scholar] [CrossRef] [PubMed]
- Tanga, C.M.; Beesigamukama, D.; Kassie, M.; Egonyu, P.J.; Ghemoh, C.J.; Nkoba, K.; Subramanian, S.; Anyega, A.O.; Ekesi, S. Performance of black soldier fly frass fertiliser on maize (Zea mays L.) growth, yield, nutritional quality, and economic returns. J. Insects Food Feed 2021, 1–12, in press. [Google Scholar] [CrossRef]
- de Souza Vandenberghe, L.P.; Garcia, L.M.B.; Rodrigues, C.; Camara, M.C.; de Melo Pereira, G.V.; de Oliveira, J.; Soccol, C.R. Potential applications of plant probiotic microorganisms in agriculture and forestry. AIMS Microbiol. 2017, 3, 629–648. [Google Scholar] [CrossRef] [PubMed]
- Mitchell, R.F.; Hanks, L.M. Insect frass as a pathway for transmission of bacterial wilt of cucurbits. Environ. Entomol. 2009, 38, 395–403. [Google Scholar] [CrossRef]
- Yang, C.C.; Kim, M.S.; Millner, P.; Chao, K.; Cho, B.K.; Mo, C.; Lee, H.; Chan, D.E. Development of multispectral imaging algorithm for detection of frass on mature red tomatoes. Postharvest Biol. Technol. 2014, 93, 1–8. [Google Scholar] [CrossRef]
- Osimani, A.; Milanović, V.; Roncolini, A.; Riolo, P.; Ruschioni, S.; Isidoro, N.; Loreto, N.; Franciosi, E.; Tuohy, K.; Olivotto, I.; et al. Hermetia illucens in diets for zebrafish (Danio rerio): A study of bacterial diversity by using PCR-DGGE and metagenomic sequencing. PLoS ONE 2019, 14, e0225956. [Google Scholar] [CrossRef] [PubMed]
- European Commission Regulation (EC) No 1069/2009 of the European Parliament and of the Council of 21 October 2009 laying down health rules as regards animal by-products and derived products not intended for human consumption and repealing Regulation (EC) No 1774/2002 (Animal by-products Regulation). Off. J. Eur. Union 2009, L 300, 1–33.
- European Commission Regulation (EU) No 142/2011 of 25 February 2011 implementing Regulation (EC) No 1069/2009 of the European Parliament and of the Council laying down health rules as regards animal by-products and derived products not intended for human consumption and implementing Council Directive 97/78/EC as regards certain samples and items exempt from veterinary checks at the border under that Directive. Off. J. Eur. Union 2011, L 54, 1–254.
- European Commission Regulation (EU) 2021/1925 of 5 November 2021 amending certain Annexes to Regulation (EU) No 142/2011 as regards the requirements for placing on the market of certain insect products and the adaptation of a containment method. Off. J. Eur. Union 2021, L 393, 4–8.
- De Smet, J.; Vandeweyer, D.; Van Moll, L.; Lachi, D.; Van Campenhout, L. Dynamics of Salmonella inoculated during rearing of black soldier fly larvae (Hermetia illucens). Food Res. Int. 2021, 149, 110692. [Google Scholar] [CrossRef]
- Shivak, D.J.; MacKenzie, K.D.; Watson, N.L.; Pasternak, J.A.; Jones, B.D.; Wang, Y.; DeVinney, R.; Wilson, H.L.; Surette, M.G.; White, A.P. A modular, Tn7-based system for making bioluminescent or fluorescent Salmonella and Escherichia coli strains. Appl. Environ. Microbiol. 2016, 82, 4931–4943. [Google Scholar] [CrossRef] [Green Version]
- Meneguz, M.; Gasco, L.; Tomberlin, J.K. Impact of pH and feeding system on black soldier fly (Hermetia illucens, L; Diptera: Stratiomyidae) larval development. PLoS ONE 2018, 13, e0202591. [Google Scholar] [CrossRef] [PubMed]
- Dijk, R.; Van den Berg, D.; Beumer, R.; de Boer, E.; Dijkstra, A.; Mout, L.; Stegeman, M.; Uyttendaele, M.; In’t Veld, S. Microbiologie Van Voedingsmiddelen—Methoden, Principes en Criteria; MYbusinessmedia: Amsterdam, The Netherlands, 2015; ISBN 978-90-72072-77-1. [Google Scholar]
- Raimondi, S.; Spampinato, G.; Macavei, L.I.; Lugli, L.; Candeliere, F.; Rossi, M.; Maistrello, L.; Amaretti, A. Effect of rearing temperature on growth and microbiota composition of Hermetia illucens. Microorganisms 2020, 8, 902. [Google Scholar] [CrossRef] [PubMed]
- Van Looveren, N.; Vandeweyer, D.; van Schelt, J.; Van Campenhout, L. Occurrence of Clostridium perfringens vegetative cells and spores throughout an industrial production process of black soldier fly larvae (Hermetia illucens). J. Insects Food Feed 2021, 1–10, in press. [Google Scholar] [CrossRef]
- Wynants, E.; Frooninckx, L.; Crauwels, S.; Verreth, C.; De Smet, J.; Sandrock, C.; Wohlfahrt, J.; Van Schelt, J.; Depraetere, S.; Lievens, B.; et al. Assessing the microbiota of black soldier fly larvae (Hermetia illucens) reared on organic waste streams on four different locations at laboratory and large scale. Microb. Ecol. 2019, 77, 913–930. [Google Scholar] [CrossRef] [PubMed]
- Gold, M.; von Allmen, F.; Zurbrügg, C.; Zhang, J.; Mathys, A. Identification of bacteria in two food waste black soldier fly larvae rearing residues. Front. Microbiol. 2020, 11, 582867. [Google Scholar] [CrossRef]
- Osimani, A.; Ferrocino, I.; Corvaglia, M.R.; Roncolini, A.; Milanović, V.; Garofalo, C.; Aquilanti, L.; Riolo, P.; Ruschioni, S.; Jamshidi, E.; et al. Microbial dynamics in rearing trials of Hermetia illucens larvae fed coffee silverskin and microalgae. Food Res. Int. 2021, 140, 110028. [Google Scholar] [CrossRef]
- Indiragandhi, P.; Anandham, R.; Madhaiyan, M.; Sa, T.M. Characterization of plant growth-promoting traits of bacteria isolated from larval guts of Diamondback moth Plutella xylostella (Lepidoptera: Plutellidae). Curr. Microbiol. 2008, 56, 327–333. [Google Scholar] [CrossRef]
- Poveda, J.; Jiménez-Gómez, A.; Saati-Santamaría, Z.; Usategui-Martín, R.; Rivas, R.; García-Fraile, P. Mealworm frass as a potential biofertilizer and abiotic stress tolerance-inductor in plants. Appl. Soil Ecol. 2019, 142, 110–122. [Google Scholar] [CrossRef]
- Vandeweyer, D.; Lievens, B.; Van Campenhout, L. Identification of bacterial endospores and targeted detection of foodborne viruses in industrially reared insects for food. Nat. Food 2020, 1, 511–516. [Google Scholar] [CrossRef]
- Talukdar, P.K.; Udompijitkul, P.; Hossain, A.; Sarker, M.R. Inactivation strategies for Clostridium perfringens spores and vegetative cells. Appl. Environ. Microbiol. 2017, 83, 1–13. [Google Scholar] [CrossRef] [Green Version]
- Warth, A.; Ohye, D.; Murrell, W. The composition and structure of bacterial spores. J. Cell Biol. 1963, 16, 579–592. [Google Scholar] [CrossRef]
- Setlow, P. Spores of Bacillus subtilis: Their resistance to and killing by radiation, heat and chemicals. J. Appl. Microbiol. 2006, 101, 514–525. [Google Scholar] [CrossRef]
- Nicholson, W.L.; Munakata, N.; Horneck, G.; Melosh, H.J.; Setlow, P. Resistance of Bacillus endospores to extreme terrestrial and extraterrestrial environments. Microbiol. Mol. Biol. Rev. 2000, 64, 548–572. [Google Scholar] [CrossRef] [Green Version]
- Fellows, J.P. Food Processing Technology: Principles and Practice, 4th ed.; Woodhead Publishers: Sawston, UK, 2016. [Google Scholar]
- Fraiha, M.; Ferraz, A.C.D.O.; Biagi, J.D. Determination of thermobacteriological parameters and size of Bacillus stearothermophilus ATCC 7953 spores. Ciência Tecnol. Aliment. 2010, 30, 1041–1045. [Google Scholar] [CrossRef] [Green Version]
- Byrne, B.; Dunne, G.; Bolton, D.J.Ã. Thermal inactivation of Bacillus cereus and Clostridium perfringens vegetative cells and spores in pork luncheon roll. Food Microbiol. 2006, 23, 803–808. [Google Scholar] [CrossRef] [PubMed]
- Grabowski, N.T.; Klein, G. Microbiology of cooked and dried edible Mediterranean field crickets (Gryllus bimaculatus) and superworms (Zophobas atratus) submitted to four different heating treatments. Food Sci. Technol. Int. 2017, 23, 17–23. [Google Scholar] [CrossRef] [PubMed]
- Corry, J.E.L.; Curtis, G.D.W.; Baird, R.M. Violet Red Bile Glucose (VRBG) agar. In Culture Media for Food Microbiology; Corry, J.E.L., Curtis, G.D.W., Baird, R.M., Eds.; Elsevier Science B.V.: Amsterdam, The Netherlands, 1995; p. 491. [Google Scholar]
- Janda, J.M.; Abbott, S.L. The Enterobacteria, 2nd ed.; ASM Press: Washington, DC, USA, 2006. [Google Scholar]
- Biswas, S.; Nazmi, A.; Pitesky, M.; Gallardo, R.; Pandey, P. Thermal inactivation of Escherichia coli and Salmonella Typhimurium in poultry carcass and litter at thermophilic temperatures. J. Appl. Poult. Res. 2019, 28, 307–317. [Google Scholar] [CrossRef]
- Van Asselt, E.D.; Zwietering, M.H. A systematic approach to determine global thermal inactivation parameters for various food pathogens. Int. J. Food Microbiol. 2006, 107, 73–82. [Google Scholar] [CrossRef] [PubMed]
- Doyle, M.E.; Mazzotta, A.S.; Wang, T.; Wiseman, D.W.; Scott, V.N. Heat resistance of Listeria monocytogenes. J. Food Prot. 2001, 64, 410–429. [Google Scholar] [CrossRef]
- Chen, Z.; Diao, J.; Dharmasena, M.; Ionita, C.; Jiang, X.; Rieck, J. Thermal inactivation of desiccation-adapted Salmonella spp. in aged chicken litter. Appl. Environ. Microbiol. 2013, 79, 7013–7020. [Google Scholar] [CrossRef] [Green Version]
- Kim, J.; Diao, J.; Shepherd, M.W.; Singh, R.; Heringa, S.D.; Gong, C.; Jiang, X. Validating thermal inactivation of Salmonella spp. in fresh and aged chicken litter. Appl. Environ. Microbiol. 2012, 78, 1302–1307. [Google Scholar] [CrossRef] [Green Version]
- Cebrián, G.; Sagarzazu, N.; Pagán, R.; Condón, S.; Mañas, P. Heat and pulsed electric field resistance of pigmented and non-pigmented enterotoxigenic strains of Staphylococcus aureus in exponential and stationary phase of growth. Int. J. Food Microbiol. 2007, 118, 304–311. [Google Scholar] [CrossRef] [PubMed]
- Chiang, M.L.; Chou, C.C. Survival of Vibrio parahaemolyticus under environmental stresses as influenced by growth phase and pre-adaptation treatment. Food Microbiol. 2009, 26, 391–395. [Google Scholar] [CrossRef] [PubMed]
- Wang, X.; Xie, Y.; Cai, H.; Duan, S.; Song, X.; Wu, Y.; Fang, T.; Dong, Q.; Liu, H. Growth and survival characteristics of Salmonella enterica regarding antibiotic resistance phenotypes. LWT 2021, 149, 111872. [Google Scholar] [CrossRef]
- Stopforth, J.D.; Suhalim, R.; Kottapalli, B.; Hill, W.E.; Samadpour, M. Thermal inactivation D- and z-values of multidrug-resistant and non-multidrug-resistant Salmonella serotypes and survival in ground beef exposed to consumer-style cooking. J. Food Prot. 2008, 71, 509–515. [Google Scholar] [CrossRef] [PubMed]

| Moment of Sampling | Microorganism | n a | c b | m c (cfu/g) | M d (cfu/g) |
|---|---|---|---|---|---|
| During or immediately after processing | Escherichia coli | 5 | 5 | 0 | 1000 |
| or | |||||
| Enterococcaceae | 5 | 5 | 0 | 1000 | |
| During or on withdrawal from storage | Salmonella | 5 | 0 | Absence in 25 g | |
| Intrinsic Parameters | |
|---|---|
| pH (-) | 7.21 ± 0.45 |
| aw (-) | 0.98 ± 0.01 |
| Moisture content (%) | 52.5 ± 0.4 |
| Microbial counts (log cfu/g) | |
| Total viable count | 9.5 ± 0.1 |
| Enterobacteriaceae | 7.7 ± 1.0 |
| Lactic acid bacteria | 8.1 ± 0.1 |
| Aerobic endospores | 6.2 ± 1.2 |
| Yeasts and molds | 4.4 ± 0.3 |
| Sulphite-reducing clostridia | <1.0 |
| Total Clostridium perfringens | <1.0 |
| Clostridium perfringens endospores | <1.0 |
| Salmonella spp. | <2.0 |
| Coagulase-positive staphylococci | 7.5 ± 0.0 |
| Inoculation Condition | Sample | Microbial Counts (log cfu/g) | |||||
|---|---|---|---|---|---|---|---|
| Total Viable Count | Aerobic Endospores | Entero-Bacteriaceae | Salmonella spp. | Total Clostridium perfringens | Clostridium perfringens Endospores | ||
| Not inoculated | Before heat treatment | 9.2 ± 0.2 b | 5.3 ± 0.0 a | 7.1 ± 0.6 b | n.d. | n.d. | n.d. |
| After heat treatment | 8.5 ± 0.3 a | 5.3 ± 0.3 a | <1.0 a | n.d. | n.d. | n.d. | |
| Inoculated with Salmonella | Before heat treatment | 9.3 ± 0.1 b | n.d. | 6.6 ± 0.4 b | 5.3 ± 0.2 b | n.d. | n.d. |
| After heat treatment | 8.3 ± 0.1 a | n.d. | <1.0 a | Absent in 25 g a | n.d. | n.d. | |
| Inoculated with Clostridium perfringens | Before heat treatment | 9.0 ± 0.3 b | 5.5 ± 0.1 b | n.d. | n.d. | 4.9 ± 0.1 b | <1.0 a |
| After heat treatment | 8.3 ± 0.1 a | 5.1 ± 0.1 a | n.d. | n.d. | <1 cfu/g a | <1 cfu/g a | |
Publisher’s Note: MDPI stays neutral with regard to jurisdictional claims in published maps and institutional affiliations. |
© 2021 by the authors. Licensee MDPI, Basel, Switzerland. This article is an open access article distributed under the terms and conditions of the Creative Commons Attribution (CC BY) license (https://creativecommons.org/licenses/by/4.0/).
Share and Cite
Van Looveren, N.; Vandeweyer, D.; Van Campenhout, L. Impact of Heat Treatment on the Microbiological Quality of Frass Originating from Black Soldier Fly Larvae (Hermetia illucens). Insects 2022, 13, 22. https://doi.org/10.3390/insects13010022
Van Looveren N, Vandeweyer D, Van Campenhout L. Impact of Heat Treatment on the Microbiological Quality of Frass Originating from Black Soldier Fly Larvae (Hermetia illucens). Insects. 2022; 13(1):22. https://doi.org/10.3390/insects13010022
Chicago/Turabian StyleVan Looveren, Noor, Dries Vandeweyer, and Leen Van Campenhout. 2022. "Impact of Heat Treatment on the Microbiological Quality of Frass Originating from Black Soldier Fly Larvae (Hermetia illucens)" Insects 13, no. 1: 22. https://doi.org/10.3390/insects13010022
APA StyleVan Looveren, N., Vandeweyer, D., & Van Campenhout, L. (2022). Impact of Heat Treatment on the Microbiological Quality of Frass Originating from Black Soldier Fly Larvae (Hermetia illucens). Insects, 13(1), 22. https://doi.org/10.3390/insects13010022

